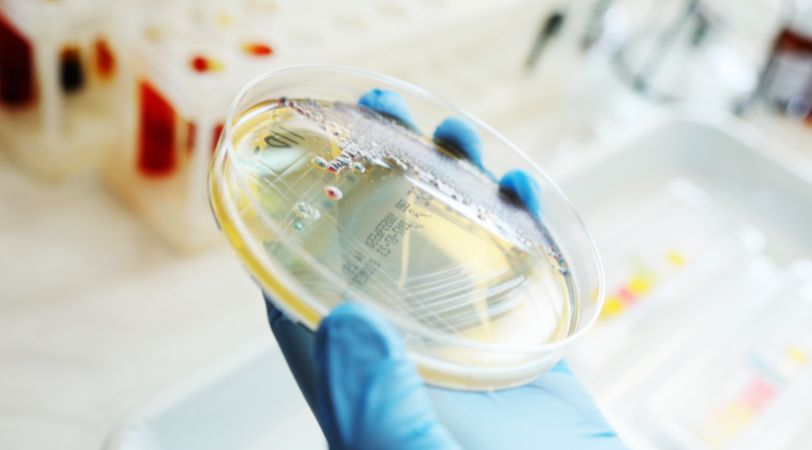

kennis
Continue een focus op een wereld in verandering.
Blijf op de hoogte van ontwikkelingen in wetgeving, kwaliteit, voedselveiligheid en duurzaamheid. Onze specialisten delen inzichten, tips en praktische handvatten voor professionals in de voedingsmiddelenindustrie.

5 min read
Taal als sleutel tot de markt
Een etiket vertelt niet alleen wát er in een product zit, maar doet dat ook in de taal van de consument. Zonder juiste vertaling kan een product simpelweg niet de markt op. Wetgeving schrijft voor dat etiketten leesbaar en begrijpelijk moeten zijn in het land van verkoop. Vertalen is daarmee niet slechts een praktische stap, maar de sleutel tot vertrouwen, veiligheid en verhandelbaarheid.

5 min read
Afspraken waarmaken, verwachtingen overtreffen
Productkwaliteit is waar belofte en praktijk samenkomen. De consument verwacht veiligheid, consistentie en smaak – de afnemer wil leverzekerheid en documentatie. De realiteit? Kwaliteit zit in de details. En in de dagelijkse keuzes die je maakt. Of het nu gaat om specificaties, klachtenopvolging of innovatie: productkwaliteit is de verbindende factor tussen afdelingen, klanten en ketenpartners. Goed geregeld geeft het vertrouwen. Slecht geregeld leidt het tot claims, verlies en frustratie.

5 min read
Beheerst veranderen is beter presteren
In een omgeving waar kwaliteit, veiligheid en compliance onder druk staan, zijn veranderingen onvermijdelijk. Nieuwe leveranciers, aangepaste processen, personele wisselingen of technologische vernieuwing. Het zijn allemaal factoren die risico’s meebrengen. Zonder duidelijke regie op verandering ontstaan onbedoelde gevolgen, fouten en verstoringen. Daarom is Management of Change (MoC) essentieel: het zorgt dat veranderingen gecontroleerd plaatsvinden, risico’s vooraf geanalyseerd worden en de juiste mensen betrokken zijn voordat de impact zich laat voelen.

5 min read
Bewijs dat producten voldoen
Voordat een product in de schappen ligt, moet het aantoonbaar voldoen aan strenge kwaliteitseisen. Retailers, toezichthouders en consumenten willen zekerheid: is dit product veilig, betrouwbaar en conform de wet? Een verhandelbaarheidsrapport geeft dat bewijs. Het combineert analyses van producteigenschappen met label- en wetgevingstoetsing. Zo ontstaat niet alleen toegang tot de markt, maar ook vertrouwen in merk en product.

5 min read
Bewijs dat telt
Een claim op een verpakking is krachtig: het beïnvloedt keuzes, bouwt vertrouwen en kan een product onderscheiden. Of het nu gaat om voedingswaarden, gezondheidsvoordelen of duurzaamheid, consumenten en toezichthouders kijken kritisch mee. Maar met kracht komt verantwoordelijkheid. Onterechte of niet-toegestane claims leiden tot sancties, reputatieschade en verlies van geloofwaardigheid. Correcte claims zijn daarom een strategisch instrument, niet alleen een juridische vereiste.

5 min read
Biodiversiteit
De natuur is ons grootste productiesysteem, maar ook het meest kwetsbare. Bodemvruchtbaarheid, bestuiving, waterkwaliteit en klimaat zijn direct verbonden aan biodiversiteit. Wanneer soorten verdwijnen, ecosystemen verarmen of grondstoffen uitputten, raakt dat ook de bedrijfsvoering van vandaag én morgen. Klanten, ketenpartners en wetgevers vragen daarom steeds vaker: wat is de impact van jouw organisatie op de natuur, en wat doe je eraan?

5 min read
De basis onder veilige verpakkingen
Elke verpakking die in contact komt met levensmiddelen moet aantoonbaar veilig zijn. De Declaration of Compliance (DoC) is hét document dat dat bewijst. Het toont aan dat jouw verpakkingsmateriaal voldoet aan de Europese en nationale regelgeving voor voedselcontactmaterialen (VCM). Maar een DoC is meer dan een formaliteit. Zonder correcte en volledige onderbouwing loop je risico’s: van non-conformiteit tot voedselveiligheidsincidenten en juridische gevolgen. Daarnaast stellen afnemers steeds vaker aanvullende eisen. Denk aan PFAS, BPA of recycleerbaarheid. Een goede DoC geeft dus niet alleen zekerheid richting toezichthouder, maar ook richting je klant.

5 min read
De bodem onder voedselveiligheid
Elk goed voedselveiligheidssysteem begint met de basis. Want zonder gestructureerde hygiëne, reiniging, onderhoud of ongediertebestrijding kun je risico’s analyseren wat je wilt, maar dan bouw je op drijfzand. Het Basisvoorwaardenprogramma (PRP) is die basis. Het is geen ‘checklistje’ in de bijlage, maar het fundament waarop elke audit, certificering én voedselveiligheidscultuur rust. Goed geregeld? Dan voorkom je incidenten, voldoe je aan de wet, en geef je medewerkers grip op hun dagelijkse praktijk.

5 min read
De onzichtbare signalen van veiligheid
In de voedingsmiddelenindustrie kan wat je níet ziet, juist het grootste risico vormen. Micro-organismen, allergenen of residuen kunnen zich ongezien nestelen in je omgeving – en uiteindelijk je product contamineren. Omgevingsmonitoring (EMP) is dé manier om dat risico structureel te beheersen. Het helpt je om: • risico’s vroegtijdig te signaleren • reiniging en desinfectie te valideren • en aantoonbaar te voldoen aan wetgeving en GFSI-standaarden Geen organisatie kan voedselveiligheid borgen zonder de omgeving mee te nemen in haar systeem.

5 min read
De PPWR | Waarom je nú in actie moet komen
Wacht niet tot handhaving of klanten u dwingen om te handelen. Start nu met een PPWR-scopebeoordeling en krijg helder inzicht in uw verantwoordelijkheden, risico’s en vervolgstappen zodat u aantoonbaar compliant bent vóór de deadlines.
5 min read
De stille kracht achter voedselveiligheid
Elke analyse die je ontvangt, van een allergenenresultaat tot een migratietest, is maar zo betrouwbaar als het systeem dat erachter zit. Laboratoriummanagement gaat over méér dan monsters analyseren. Het gaat over het structureren, borgen en optimaliseren van processen die cruciaal zijn voor voedselveiligheid, kwaliteit en besluitvorming. Goed labbeheer betekent: betrouwbare resultaten, minimale foutkansen en maximale waarde uit data. En dat begint bij compliance – maar eindigt bij continuïteit.

5 min read
De structuur achter vertrouwen
Kwaliteit is geen toeval. Het is het resultaat van heldere processen, gedeelde verantwoordelijkheid en structurele borging. Kwaliteitssystemen vormen het fundament onder voedselveiligheid, productkwaliteit en bedrijfsintegriteit. Ze zorgen ervoor dat je werkt volgens wetgeving, klanteisen en internationale standaarden en dat je dat ook kunt aantonen. Maar kwaliteitssystemen zijn méér dan een middel om gecertificeerd te zijn. Ze vormen de basis voor verbetering, voor vertrouwen, en voor strategische keuzes die toekomstbestendigheid versterken.

5 min read
Duurzaamheid verankeren in structuur én gedrag
Duurzaamheid is geen project. Het is een visie die je moet organiseren, borgen en meetbaar maken. Niet alleen om te voldoen aan wet- en regelgeving, maar om doelgericht te bouwen aan impact – met resultaat voor mens, milieu én organisatie. Een ESG- of duurzaamheidsmanagementsysteem maakt duurzaamheid onderdeel van je structuur. Het brengt samenhang, zorgt voor continuïteit en maakt het mogelijk om voortgang aantoonbaar te volgen, bij te sturen én te verbeteren.

5 min read
Elke fout is een kans, als je hem oppakt
In een wereld van certificeringen, standaarden en processen is er één waarheid die blijft gelden: áls er iets misgaat, wil je het snel weten – en duurzaam oplossen. Klachten en afwijkingen vormen waardevolle signalen. Ze vertellen waar het systeem tekortschiet, waar verwachtingen niet zijn waargemaakt en waar verbetering mogelijk is. Mits je ze serieus neemt. Een klacht die niet wordt opgepakt, wordt herhaald. Een afwijking die niet wordt begrepen, keert terug.

5 min read
ExpertDesk - Antwoorden die verder gaan
Niet elke vraag heeft een standaardantwoord. Soms loop je tegen complexe kwesties aan waar wetgeving, praktijk en strategie samenkomen. De ExpertDesk is er voor precies die momenten. Hier bundelen we kennis uit verschillende expertises en maken we ingewikkelde vraagstukken begrijpelijk en toepasbaar. Het doel: zekerheid, inzicht en richting voor organisaties die niet genoegen nemen met halve antwoorden.

5 min read
Gedrag als fundament van voedselveiligheid
De meeste bedrijven beschikken over heldere protocollen, systemen en certificeringen. Toch ontstaan de grootste risico’s vaak niet in het systeem, maar in de uitvoering. In het gedrag. Want voedselveiligheid is geen checklist die je afvinkt, het is een cultuur die je leeft – elke dag, op elke plek in de organisatie. Food Safety Culture (FSC) draait om hoe medewerkers denken over voedselveiligheid, hoe ze ermee omgaan in hun dagelijkse werk en hoe ze reageren wanneer het spannend wordt. Het is zichtbaar in kleine keuzes, in voorbeeldgedrag van leidinggevenden, en in de manier waarop fouten besproken worden. Een sterke FSC is geen bijzaak. Het is een essentiële voorwaarde voor vertrouwen, continuïteit en groei.

5 min read
Gezond, betrokken en toekomstbestendig
Mensen maken je organisatie. De manier waarop je met hen omgaat – op het gebied van gezondheid, veiligheid, werkdruk en ontwikkeling – is bepalend voor kwaliteit, continuïteit én reputatie. Binnen duurzaamheidsbeleid wordt de rol van personeel steeds centraler: van wettelijke arbo-eisen naar strategische inzet op welzijn, werkgeluk en duurzame inzetbaarheid. Wie goed voor mensen zorgt, bouwt aan vertrouwen, betrokkenheid en prestaties. Niet alleen omdat het moet – maar omdat het werkt.

5 min read
Grip op data, zekerheid in de keten
Productinformatie is de ruggengraat van de voedingsmiddelenindustrie. Van ingrediënten en allergenen tot verpakkingsdetails: retailers, toezichthouders en consumenten verwachten correcte en actuele data. Een goed ingericht specificatiebeheersysteem voorkomt fouten, versnelt processen en versterkt vertrouwen in de hele keten. Voor producenten én retailers is het dé sleutel tot transparantie en continuïteit.

5 min read
Grip op je waardevolste grondstof
Water is een van de meest essentiële hulpbronnen in de voedingsmiddelenindustrie – maar ook een van de meest kwetsbare. Schaarste, verbruik, vervuiling en stijgende kosten dwingen organisaties om bewuster, efficiënter en aantoonbaarder met water om te gaan. Waterbeheer is daarom geen technische randvoorwaarde, maar een strategisch thema. Of het nu gaat om gebruik, lozing of hergebruik – inzicht en actie zijn cruciaal voor continuïteit, compliance én duurzaamheid.

5 min read
Grip op kwaliteit begint bij structuur
Of het nu gaat om procedures, instructies, certificaten of inspectielijsten: kwaliteit staat of valt met de juiste informatie op het juiste moment, op de juiste plek. Zonder goed documentatiebeheer ontstaan fouten, worden audits stressvol en wordt naleving afhankelijk van toeval in plaats van structuur. Een goed ingericht systeem voor documentbeheer zorgt voor rust, duidelijkheid en continuïteit. Voor iedereen die werkt aan voedselveiligheid en kwaliteit.

5 min read
Inzicht, integriteit en controle in de keten
In de voedingsindustrie is snelheid cruciaal. Zeker als er iets misgaat. Of het nu gaat om een recall, een voedselveiligheidsincident of een klantvraag over herkomst. Je moet weten: waar komt dit product vandaan, en waar is het naartoe gegaan? Traceerbaarheid is daarom meer dan een wettelijke verplichting. Het is de ruggengraat van voedselveiligheid, kwaliteitsborging en ketentransparantie. Zonder goed systeem heb je geen grip. Met een goed systeem heb je controle, vertrouwen en veerkracht.

5 min read
Klaar voor de nieuwe standaard in verpakkingswetgeving
De Packaging and Packaging Waste Regulation (PPWR) is de nieuwe Europese verordening die verpakkingen structureel moet verduurzamen. Met verplichte eisen rondom recycleerbaarheid, herbruikbaarheid, verpakkingsvolumes en afvalreductie, heeft deze wetgeving grote impact op producenten, retailers en importeurs. bedrijven moeten aantonen dat hun verpakkingen voldoen aan de PPWR. Niet alleen om boetes of handelsbelemmeringen te voorkomen, maar ook om relevant en verantwoord te blijven opereren binnen een circulaire economie.

5 min read
Kwaliteit geborgd, vertrouwen verdiend
Kwaliteit ontstaat niet vanzelf. Het is het resultaat van heldere afspraken, scherpe keuzes en structurele borging. In een sector waarin voedselveiligheid, wetgeving en reputatie samenkomen, is governance de sleutel: het raamwerk waarmee organisaties sturen op naleving én groei. Governance betekent niet alleen documenteren wat moet. Het betekent organiseren wat telt: beleid, KPI’s, processen, verantwoordelijkheden en leiderschap. Zodat kwaliteit niet stopt bij QA, maar onderdeel wordt van de hele organisatie.

5 min read
Kwaliteit gegarandeerd, veiligheid geborgd
In de levensmiddelenindustrie draait alles om vertrouwen. Vertrouwen dat producten veilig zijn, voldoen aan wetgeving, klanteisen én jouw eigen kwaliteitsnormen. Dat vertrouwen ontstaat niet vanzelf. Het wordt opgebouwd via kwaliteitsborging (QA) en kwaliteitscontrole (QC) – de structuur en praktijk waarmee processen worden beheerst, verbeterd en geborgd. QA/QC is geen losstaande functie, maar een samenspel van beleid, checks, registraties, verificaties én cultuur. Wanneer deze elementen goed zijn ingericht, maken ze kwaliteit aantoonbaar en voedselveiligheid robuust.

5 min read
Logo’s die vertrouwen wekken
Logo’s op verpakkingen zijn meer dan visuele accenten: ze dragen betekenis. Ze wekken vertrouwen bij consumenten, geven richting aan keuzes in de supermarkt en tonen naleving van normen en standaarden. Maar een verkeerd gebruikt of onjuist logo kan het tegenovergestelde effect hebben – verwarring, twijfel of zelfs juridische problemen. Correct labelen is daarmee niet alleen een kwestie van naleving, maar van merkwaarde en geloofwaardigheid.

5 min read
Meten wat telt, waar het telt
Controle begint bij inzicht. En inzicht begint bij meten. Een goed opgezet monsternameplan vormt de basis voor aantoonbare voedselveiligheid en productkwaliteit. Of het nu gaat om grondstoffen, eindproducten of omgevingshygiëne – zonder planmatige bemonstering blijft elk laboratoriumresultaat slechts een momentopname zonder context. Het juiste monster, op het juiste moment, met de juiste reden. Dát is waar een monsternameplan voor staat.

5 min read
Omdat stilstaan geen optie is
Veranderen is onvermijdelijk. Grondstoffen wisselen van kwaliteit, personeel verandert, richtlijnen worden aangescherpt en verwachtingen blijven groeien. Organisaties die hier actief op inspelen, blijven sterk. Organisaties die afwachten, raken achterop. Continue verbetering is geen project of protocol. Het is een manier van denken én doen. Het helpt organisaties om gericht te leren, aan te passen en sterker uit veranderingen te komen. Niet omdat het moet, maar omdat het waarde creëert: voor de klant, voor de medewerker en voor de toekomst.

5 min read
Sterk op het moment dat het telt
Incidenten komen altijd onverwacht. Een afwijking in de productielijn, een terugroepactie, cyberaanval of een plotselinge ketenverstoring. De impact op kwaliteit, continuïteit en vertrouwen kan groot zijn. Juist dan wil je kunnen vertrouwen op structuur, overzicht en daadkracht. Een incident is geen kwestie van of, maar wanneer. De manier waarop je erop voorbereid bent, maakt het verschil tussen schade beperken of schade vergroten. En tussen herstellen of sterker terugkomen.

5 min read
Taal als sleutel tot de markt
Een etiket vertelt niet alleen wát er in een product zit, maar doet dat ook in de taal van de consument. Zonder juiste vertaling kan een product simpelweg niet de markt op. Wetgeving schrijft voor dat etiketten leesbaar en begrijpelijk moeten zijn in het land van verkoop. Vertalen is daarmee niet slechts een praktische stap, maar de sleutel tot vertrouwen, veiligheid en verhandelbaarheid.

5 min read
Transparantie over herkomst, verantwoordelijkheid over impact
Ontbossing is wereldwijd één van de grootste veroorzakers van biodiversiteitsverlies en klimaatverandering. Europa pakt dit nu structureel aan met de nieuwe EU Deforestation Regulation (EUDR). Vanaf eind 2024 mogen producten als cacao, soja, palmolie, koffie, rubber, rundvlees en hout alléén nog op de Europese markt komen als ze aantoonbaar niet bijdragen aan ontbossing. Voor organisaties betekent dit: ketens inzichtelijk maken, risico’s beheersen en gegevens structureel vastleggen. Niet alleen voor compliance, maar ook voor geloofwaardigheid.

5 min read
Transparantie tot op ingrediëntniveau
Additieven zijn onmisbaar in veel voedingsproducten: ze verlengen houdbaarheid, verbeteren smaak of zorgen voor de juiste structuur. Maar elk additief dat wordt toegepast, staat onder toezicht van strenge wetgeving. Consumenten verwachten duidelijkheid, toezichthouders eisen naleving. Het gebruik van additieven is daarmee niet alleen een technologische keuze, maar ook een kwestie van vertrouwen en compliance.







